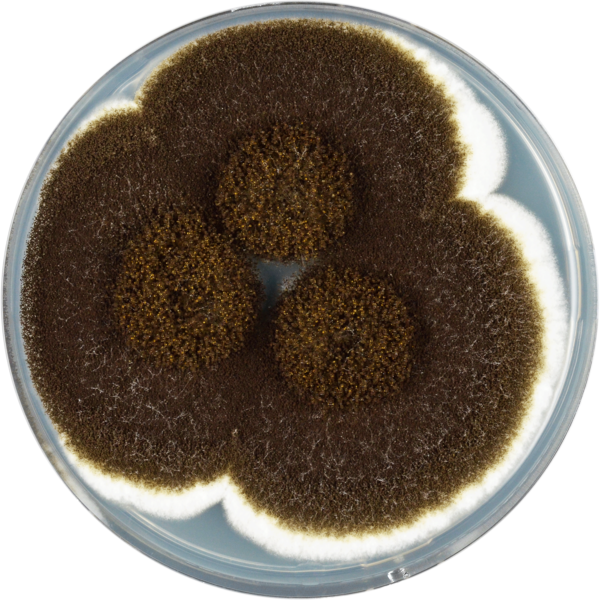
Aspergillus Heteromorphus Cya - Aspergillus (600x600), Png Download

Aspergillus Heteromorphus Cya - Aspergillus
Share
: Aspergillus Heteromorphus Cya - Aspergillus
Format: PNG
Dimensions: 600x600 px
Size: 634 KB
Downloads: 3
Report image
A high-quality creative community needs everyone's contribution. The shared material of Aspergillus Heteromorphus Cya - Aspergillus is a free 600x600 PNG picture with no background, This PNG image is high resolution and very popular on the public internet. You can download it for free and use it for personal non-commercial use. Aspergillus Heteromorphus Cya - Aspergillus belongs to the category null.
Short Link (Direct Image Link)
Code for Inserting an Image for Your Blog or Website